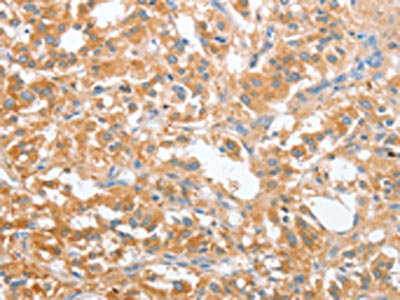

CD200R1 Antibody
-
中文名稱:CD200R1兔多克隆抗體
-
貨號:CSB-PA903031
-
規(guī)格:¥1100
-
圖片:
-
The image on the left is immunohistochemistry of paraffin-embedded Human liver cancer tissue using CSB-PA903031(CD200R1 Antibody) at dilution 1/60, on the right is treated with fusion protein. (Original magnification: ×200)
-
The image on the left is immunohistochemistry of paraffin-embedded Human thyroid cancer tissue using CSB-PA903031(CD200R1 Antibody) at dilution 1/60, on the right is treated with fusion protein. (Original magnification: ×200)
-
-
其他:
產(chǎn)品詳情
-
Uniprot No.:
-
基因名:
-
別名:CD 200R antibody; CD200 cell surface glycoprotein receptor antibody; CD200 receptor 1 antibody; Cd200r1 antibody; Cell surface glycoprotein CD200 receptor 1 antibody; Cell surface glycoprotein OX2 receptor 1 antibody; Cell surface glycoprotein OX2 receptor antibody; cell surface glycoprotein receptor CD200 antibody; CRTR 2 antibody; CRTR2 antibody; HCRTR2 antibody; MO2R1_HUMAN antibody; MOX2 receptor antibody; MOX2R antibody; OX2R antibody
-
宿主:Rabbit
-
反應種屬:Human
-
免疫原:Fusion protein of Human CD200R1
-
免疫原種屬:Homo sapiens (Human)
-
標記方式:Non-conjugated
-
抗體亞型:IgG
-
純化方式:Antigen affinity purification
-
濃度:It differs from different batches. Please contact us to confirm it.
-
保存緩沖液:-20°C, pH7.4 PBS, 0.05% NaN3, 40% Glycerol
-
產(chǎn)品提供形式:Liquid
-
應用范圍:ELISA,IHC
-
推薦稀釋比:
Application Recommended Dilution ELISA 1:2000-1:5000 IHC 1:50-1:200 -
Protocols:
-
儲存條件:Upon receipt, store at -20°C or -80°C. Avoid repeated freeze.
-
貨期:Basically, we can dispatch the products out in 1-3 working days after receiving your orders. Delivery time maybe differs from different purchasing way or location, please kindly consult your local distributors for specific delivery time.
-
用途:For Research Use Only. Not for use in diagnostic or therapeutic procedures.
相關產(chǎn)品
靶點詳情
-
功能:Inhibitory receptor for the CD200/OX2 cell surface glycoprotein. Limits inflammation by inhibiting the expression of proinflammatory molecules including TNF-alpha, interferons, and inducible nitric oxide synthase (iNOS) in response to selected stimuli. Also binds to HHV-8 K14 viral CD200 homolog with identical affinity and kinetics as the host CD200.
-
基因功能參考文獻:
- Reduced expression of monocyte CD200R is associated with enhanced proinflammatory cytokine production in sarcoidosis PMID: 27929051
- we demonstrated for the first time that CD200R is highly expressed on cells involved in type 2 immune responses, namely on Th2, Tc2, ILC2, and basophils. All these cell types play a role in type 2 inflammation. PMID: 28106273
- Residual CD200 activity may prevent completion of abortions via induction of Treg cells. In chronic histiocytic intervillositis, infiltrating maternal effector T cells may block Treg induction. An autocrine role for CD200-CD200R interaction versus inhibition of soluble CD200 by soluble CD200R is discussed. PMID: 28326648
- MMP12-producing monocyte-derived cells in gingival tissue of periodontitis patients also had reduced CD200R surface levels. Treatment with a CD200R ligand reduced CSF2-induced MMP12 production in these cells. This novel association of the CD200/CD200R pathway with MMP12 production by monocyte-derived cells may play a key role in PD progression. PMID: 29101312
- Coexpression of CD200R-CD28 enhances function in WT1-specific T-cell receptor - transduced human primary T cells. PMID: 29042364
- Our findings suggest a promising role of CD200R as a prognostic marker in predicting elevated recurrence and reduced survival, and a potential therapeutic target in treating hepatocellular carcinoma. PMID: 27562325
- we revealed a critical role for CD200R signaling in limiting the growth and metastasis of CD200(+) tumors. PMID: 27385779
- Constitutively expressed Siglec-9 inhibits LPS-induced CCR7, but enhances IL-4-induced CD200R expression in human macrophages. PMID: 26923638
- Inflammatory Bowel Disease patients showed a significant decrease in the percentage of plasmacytoid dendritic cells and myeloid dendritic cells expressing CD200R1 compared to that of the control group. PMID: 26690123
- CD200-CD200R1 signaling may be required for human pregnancy success. PMID: 26123445
- This is the first report of CD200R1 expression by human epithelial tumor cells, and specifically, early-stage human breast cancer cells. It is also the first report of CD200R1 expression by term placental villous trophoblasts. PMID: 26011475
- data show that the expression of CD200R, CD95 and CD95L was influenced by cardiac surgery and imply the role of these membrane molecules in cell regulation-inhibition and apoptosis following cardiac surgery. PMID: 25404054
- The authors showed that the viral orthologues e127 from rat cytomegalovirus and K14 from human herpesvirus 8 do not bind the activating CD200R-like proteins from their respective species, although they do bind the inhibitory receptors. PMID: 26538068
- The proportion of CD200R1+ cells in PBMCs, peripheral CD14+ cells and CD4+ T cells was significantly lower in rheumatoid arthritis patients compared to controls. PMID: 25261692
- We demonstrate a significant correlation between CD200R1 positive cells and disease severity in rheumatoid arthritis (RA) patients, thus indicating the relevance of the CD200/CD200R1 signaling pathway potential involvement in the pathogenesis of RA. PMID: 24496593
- The mechanism underlying ESA might be associated with enhanced expression of CD200 and CD200R in the trophoblast, leading to an upregulation of the immune response during the first trimester of pregnancy. PMID: 25145957
- The expression of CD200R as well as B7-H4 co-stimulatory molecules on CD14(+) cells were significantly higher in cord blood when compared with peripheral blood. PMID: 23066977
- Measurement of sCD200 and/or sCD200R1 may prove a useful and rapid means of monitoring subjects at risk of bone loss. PMID: 24333170
- [review] CD200R1 is comparable to other pathogen-targeted inhibitory receptors; its signaling pathway is utilized by a diverse number of pathogens and represents a novel targeting strategy for infectiouis diseases. PMID: 24388216
- Mesenchymal stem cells, through the expression of CD200, play a major role in the regulation of bone resorption and bone physiology and the CD200-CD200R couple could be a new target to control bone diseases. PMID: 23940819
- The expression of CD200 and its receptor, CD200R, on CD83+ monocyte-derived dendritic cells (Mo-DCs), pulsed or not with autologous tumor cell lysates (aTCL) in patients who suffer from laryngeal carcinoma, were examined. PMID: 23690219
- blocking CD200 on tumor cells may have opposite effects on tumor proliferation depending on the "affinity" of the macrophages to form the CD200-CD200R-complex with tumor cells. PMID: 23541619
- CD200 and CD200R1 expression and function are abnormal in systemic lupus erythematosus PMID: 22621248
- in cutaneous squamous cell carcinoma, CD200 expression on local blood vessels may promote tumor progression by suppressing CD200R myeloid cells during diapedesis PMID: 23560298
- Mesenchymal stromal cells are able to modulate the expression of both CD200 and CD200R on some T-cells. PMID: 22575528
- these results indicate a role of CD200R:CD200 in T cell responses to helminths which has diagnostic and prognostic relevance as a marker of infection for chronic schistosomiasis in mouse and man. PMID: 22496920
- Mechanistically, Kaposi's sarcoma-associated herpesvirus viral OX2 protein and CD200 expression on antigen presenting cells suppressed the phosphorylation of ERK1/2 mitogen-activated protein kinase in responding T cells. PMID: 22491458
- The role of the CD200-CD200R axis in bone marrow-derived mesenchymal stem cell mediated immunosuppression was studied using THP-1 human macrophages. PMID: 22363701
- Dok1 negatively regulates Dok2-mediated CD200R signaling through the recruitment of CrkL. PMID: 21078907
- results suggest an intrinsic abnormality in the CD200-CD200R signaling in monocyte-derived macrophages during aging and, especially, in Parkinson disease PMID: 19924532
- The CD200 receptor gene family resembles the signal regulatory proteins and killer Ig-related receptors in having receptor family members with potential activatory and inhibitory functions that may play important roles in immune regulation and balance. PMID: 12960329
- Human Herpesvirus-8 K14 protein interacts with human CD200R during the lytic cycle. Despite sharing only 40% primary sequence identity, K14 and CD200 interacts with CD200R with an almost identical and low affinity (K(D) = 0.5 microM) PMID: 15220441
- CD200R represents a novel and potent inhibitory receptor that can be targeted in vivo to regulate mast cell-dependent pathologies. PMID: 15661892
- Human CD200R is an important regulatory molecule of basophil activation. PMID: 16177086
- Reactions with CD200 antigen modulate immunomodulation for prevention of undesired immune responses of the skin. PMID: 16354172
- In human tonsils, CD200R is differentially expressed on B cells, with high expression on memory cells and plasmablasts. PMID: 17714785
- Review highlights the close correlation between CD200-CD200 receptor (CD200R), microglia activation, and Parkinson's disease. PMID: 18040859
- The CD200-CD200R pathway seems of critical relevance for macrophage-mediated damage in autoimmune inflammation of the CNS. PMID: 18164423
- CD200-mediated immune suppression may occur not only via neuron-microglia interactions, but also via glia-glia interactions, especially in inflammatory conditions in which an immune-suppressive environment needs to be restored. PMID: 19151626
- CD200R inhibits the activation of human myeloid cells through direct recruitment of Dok2 and subsequent activation of RAS p21 protein activator 1. PMID: 19786546
顯示更多
收起更多
-
亞細胞定位:[Isoform 1]: Cell membrane; Single-pass type I membrane protein.; [Isoform 4]: Cell membrane; Single-pass type I membrane protein.; [Isoform 2]: Secreted.; [Isoform 3]: Secreted.
-
蛋白家族:CD200R family
-
組織特異性:Expressed in granulocytes, monocytes, most T-cells, neutrophils, basophils and a subset of NK, NKT and B-cells (at protein level). Expressed in bone marrow, lymph nodes, spleen, lung, liver, spinal cord, kidney. Expressed in monocyte-derived dendritic and
-
數(shù)據(jù)庫鏈接:
Most popular with customers
-
-
YWHAB Recombinant Monoclonal Antibody
Applications: ELISA, WB, IHC, IF, FC
Species Reactivity: Human, Mouse, Rat
-
Phospho-YAP1 (S127) Recombinant Monoclonal Antibody
Applications: ELISA, WB, IHC
Species Reactivity: Human
-
-
-
-
-